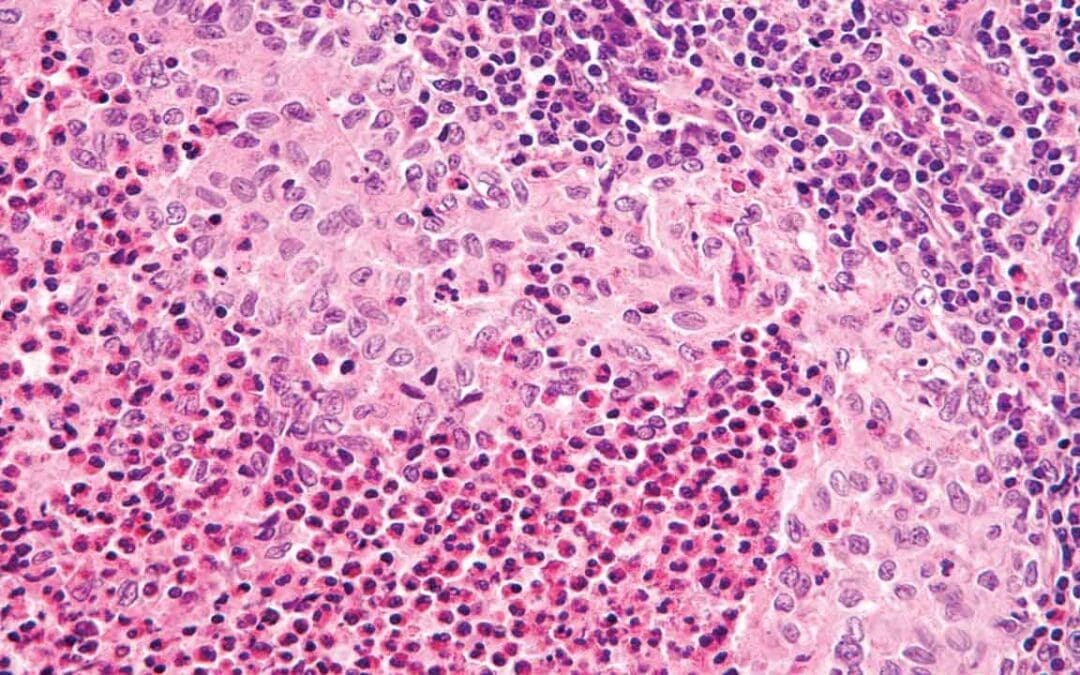
Langerhans Cell Histiocytosis (Histiocytosis X)

by MyH Editorial Team | Mar 30, 2026 | White Blood Cells
Key Takeaways Langerhans Cell Histiocytosis or formerly known as Histiocytosis X is a clonal myeloid neoplasm characterized by the proliferation of abnormal cells resembling Langerhans cells. It is driven by inflammatory signaling rather than simple cell mass....

by MyH Editorial Team | Mar 25, 2026 | White Blood Cells
Key Takeaways Tumor Lysis Syndrome or TLS is a life-threatening oncologic emergency caused by the rapid, massive lysis of malignant cells. This releases intracellular contents (potassium, phosphorus, and nucleic acids) into the systemic circulation, overwhelming...

by MyH Editorial Team | Mar 17, 2026 | White Blood Cells
Key Takeaways Hemophagocytic Lymphohistiocytosis or HLH is a life-threatening “cytokine storm” where a broken “off-switch” in the immune system leads to unchecked, hyperactive T-cells and macrophages that attack the patient’s own...

by MyH Editorial Team | Mar 9, 2026 | White Blood Cells
Key Takeaways Neutropenic sepsis is a medical emergency defined by a fever (≥ 38.3°C (101°F)) and an ANC < 0.5 X 109/L. It requires a “door-to-needle” time of < 60 minutes for the first dose of broad-spectrum antibiotics....

Recent Comments